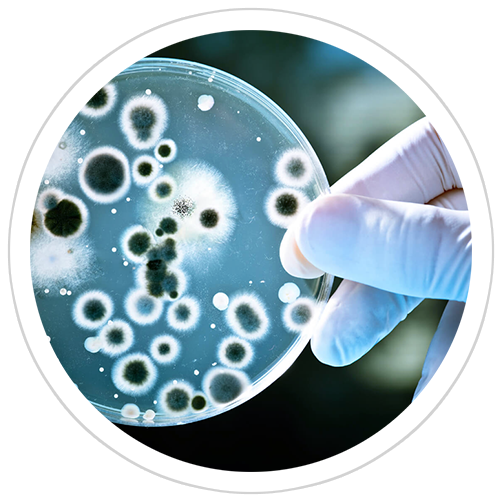

改變
菌叢生態
Severity: Notice
Message: Undefined index: HTTP_ACCEPT_LANGUAGE
Filename: controllers/Pages.php
Line Number: 21
Backtrace:
File: /home/bradchao/public_html/application/controllers/Pages.php
Line: 21
Function: _error_handler
File: /home/bradchao/public_html/index.php
Line: 315
Function: require_once

改變
菌叢生態

調節
生理機能

以天然無毒抗性澱粉為原料,經酵素移轉工程研製而成,
能促進腸內雙歧桿菌(Bifidobacterium),改變菌叢生態,
幫助維持消化道機能,有效調節生理機能。
做好體內環保,天天擁有好精神、好氣色!
成份:異麥芽寡醣97.5﹪± 2﹪,含
般若醣(Panose)39.5﹪
異麥芽(Isomaltose)16.3﹪
異麥芽三醣(lsomaltotriose)19.4﹪
異麥芽四醣以上(more than Isomaltotetraose)22.3﹪

2014年
榮獲新加坡「亞洲科學家」雜誌
評選為「世界第一」的殊榮。
每日1-2次
每次5-10公克
(一瓢約5公克)